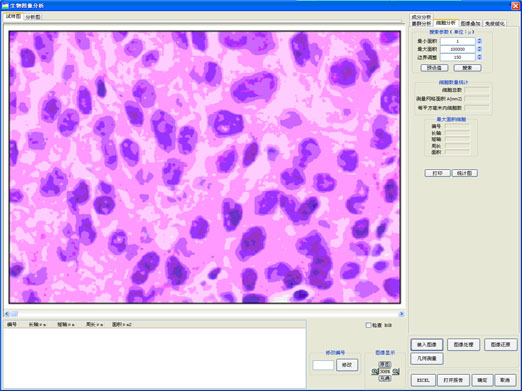

生物分析軟件
生物分析軟件介紹:
GM-SW2000生物分析軟件系統(tǒng)是上海光密儀器公司為醫(yī)學(xué)檢驗的單位或個人專門開發(fā)的一套計算機軟件系統(tǒng),生物分析軟件主要模塊有細胞分析,菌群分析,成分分析,顆料分析,免疫組化,圖像疊加等功能。它的基本原理是:計算機圖像處理系統(tǒng)所采集的圖像都有一個固定的X-Y比例,它是由生物顯微鏡、攝像頭、圖像采集卡、計算機、處理軟件、采集圖像分辨率、顯示器分辨率等軟、硬件環(huán)境共同決定的,其數(shù)據(jù)的含義是: 在當(dāng)前的軟、硬件條件下,顯示器的一個像素,代表的實際長度值。應(yīng)用圖像軟件進行圖像分析時,必須先設(shè)定當(dāng)前環(huán)境下的硬件參數(shù),才能保證系統(tǒng)測量數(shù)據(jù)的真實性和準(zhǔn)確性,否則,得出的結(jié)果將不準(zhǔn)確。當(dāng)軟、硬件環(huán)境發(fā)生變化后,該參數(shù)必須作相應(yīng)的變更。參數(shù)測得后,應(yīng)使用本軟件的"幾何測量"功能,對已知尺寸的測微尺圖像進行測量,以驗證數(shù)據(jù)的準(zhǔn)確性。用視頻采集卡或數(shù)碼相機等硬件設(shè)備,采集到顯微鏡中的偏光圖片,再對該圖片進行處理和分析,得到相關(guān)檢驗結(jié)果。
系統(tǒng)配置需求:
l 中央處理器CPU: 2.0G及以上
l 內(nèi)存Mem: 512MB以上 配獨立顯卡
l 硬盤HD: 200MB以上剩余空間
l 操作系統(tǒng): Win2000,WinXP,Win7(32位)
l USB接口(加密狗需要使用)。
l GM-SW2000生物分析軟件的視頻捕捉部分,需要有視頻捕捉硬件設(shè)備,如電腦型生物顯微鏡或電腦型熒光顯微鏡等才能工作。最好在安裝本軟件前安裝視頻捕捉硬件。
l GM-SW2000生物分析軟件要有隨軟件一起的軟件加密狗(USB)才能正常工作。請在安裝完本軟件后將USB加密狗安裝到計算機的USB口中。
GM-SW2000生物分析軟件操作界面:

GM-SW2000功能介紹:
l 圖像捕捉:從顯微視頻捕捉卡上捕捉圖像,用于測量,保存。
l 打開文件:打開已存在的圖像文件用于測量,支持BMP圖像格式和JPG格式。
l 定標(biāo):確定圖像尺寸與真實尺寸的比例,一般在圖像測量之前。
l 定標(biāo)分兩個方向:水平方向和垂直方向。只有兩個方向都定標(biāo)之后,標(biāo)尺才能最后確保所測量數(shù)據(jù)為實際尺寸。
l 自動分析:用戶可通過該功能分析細菌圖像中細菌的長度、直徑、體積、個數(shù)和每個細菌的幾何參數(shù)。
l 圖像的處理、保存、打印:本軟件提供了數(shù)十種圖像處理功能,同時可對圖像進行保存,以及按指定放大倍數(shù)打印,整個過程都在計算機上完成,可充分發(fā)揮計算機強大的信息處理功能,具有許多傳統(tǒng)人工方法所無法比擬的優(yōu)勢。
l 幾何測量:本軟件提供了"直線"、"矩形"、"圓"、"多邊形"、"角度"等測量工具,可在圖片上完成長度、面積、角度等測量工作。
l 報告文件的生成、保存、打印:可按用戶需求制作報告文檔的錄入界面、軟件可自動生成電子報告文檔,并提供報告的保存和打印功能。
GM-SW2000生物圖像分析軟件-模塊:
l 細胞分析
l 菌群分析
l 成分分析
l 顆料分析
l 免疫組化
l 圖像疊加
l 圖像測量
GM-SW2000生物分析軟件案例圖:
模塊1 :菌群圖像分析:
稀疏菌群搜索

密集菌群搜索

模塊2:細胞圖像分析:
模塊3:圖像疊加:
1裝入圖像

② 目標(biāo)捕獲

③ 目標(biāo)搜索

④ 圖像疊加

模塊4:免疫組化:

模塊5:成分分析:

模塊6:顆粒分析:

分區(qū)統(tǒng)計:

- 上一篇:沒有了
- 下一篇:清潔度分析軟件







